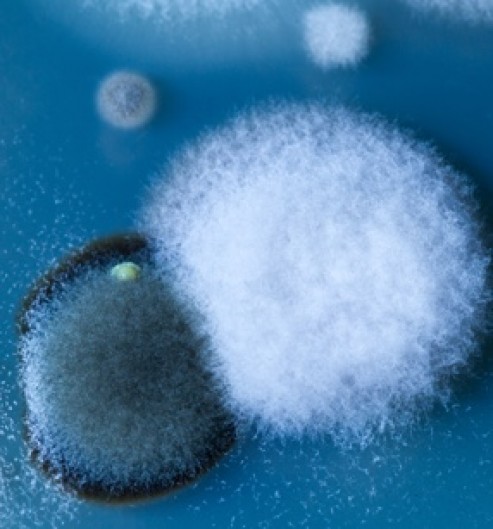

Allergic rhinitis
What is allergic rhinitis?
Allergic rhinitis, or hay fever, is the result of an allergic response of our body to specific allergens.
Up to 30 percent of people worldwide are affected. Allergens are harmless substances that cause allergic reactions. The most common example of an allergen is pollen, usually the cause for seasonal allergic rhinitis, which usually appears when the season changes.